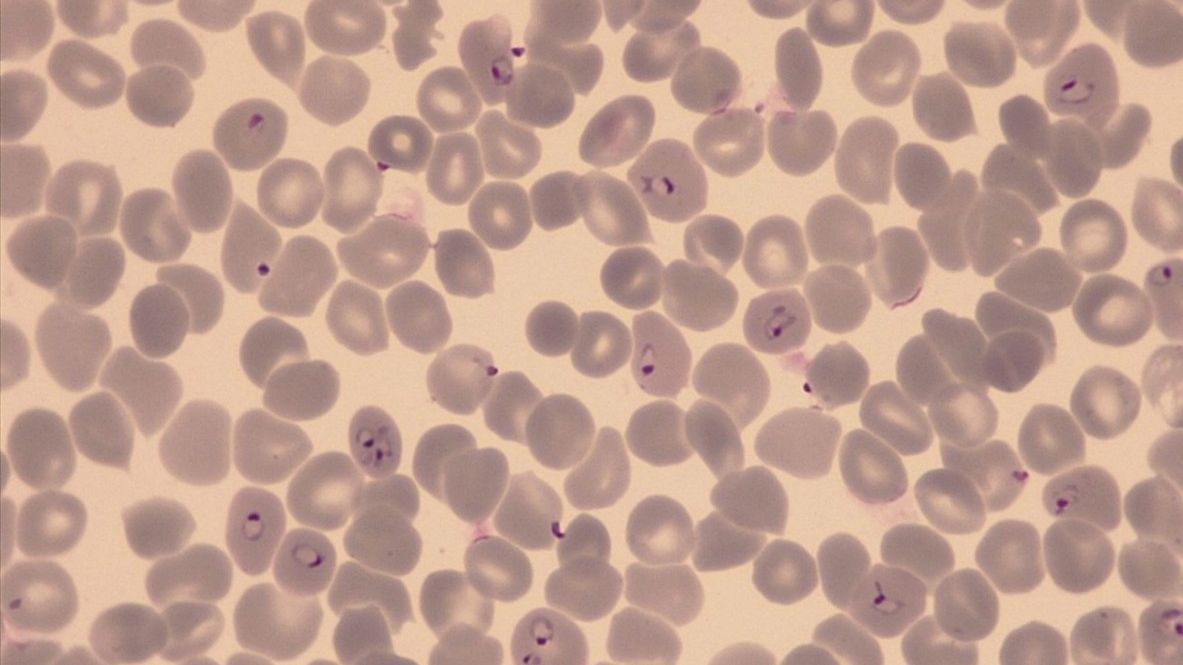
Red blood cells infected with P. falciparum (Photo: A. Passecker) Red blood cells infected with P. falciparum (Photo: A. Passecker)

Antimalarial drug development
Treating malaria is a global challenge. Resistance against artemisinin-based combination therapies has recently been detected in Southeast Asia, threatening the impact of standard therapies on malaria. Developing new and highly efficient antimalarials is, therefore, urgently needed. Swiss TPH has a long and successful track record in antimalarial drug development. We are among the leading institutions in assay development and drug discovery. Our in vitro and in vivo models globally support the preclinical development of new antimalarials. Clinical research is carried out in endemic countries of tropical Africa.
Selected projects
New hope against drug-resistant malaria
As malaria parasites increasingly evade existing treatments, researchers from Swiss TPH, the Helmholtz Institute for Pharmaceutical Research Saarland (HIPS) and partners have discovered a promising new drug candidate capable of killing resistant strains of Plasmodium falciparum.
The compound – identified from BASF’s extensive chemical library – works through a novel biological mechanism that blocks the parasite’s ability to make essential proteins. Early tests show it is highly effective against malaria parasites while being non-toxic to human cells.
By targeting the parasite in a completely new way, this discovery could pave the path for next-generation antimalarial therapies that remain effective where current medicines fail. Read more

Drug discovery for malaria
The NGBS programme in malaria drug discovery is a collaboration between public and private research institutes. This programme aims at solving two fundamental medical needs. Firstly, a one dose cure for P. falciparum malaria would be a breakthrough in solving compliance problems and would also contribute to easing logistical and cost issues. Also new molecules are needed to replace older ones that are increasingly rendered ineffective through resistance. Secondly, an attempt is made to identify targets that allow achieving effective cures for P. vivax infections.
